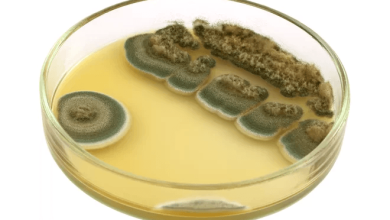

La mantequilla de mar, también conocida como «mantequilla de algas» o «mantequilla de algas marinas», es un tipo de alga comestible que ha ganado popularidad en los últimos tiempos debido a sus presuntos beneficios para la salud y su sabor único. Sin embargo, al igual que con cualquier alimento, es importante comprender tanto sus beneficios como sus posibles riesgos antes de incorporarlo a tu dieta regular.
Beneficios de la mantequilla de mar:
-
Fuente de nutrientes esenciales: La mantequilla de mar es rica en una variedad de nutrientes importantes para la salud, incluyendo vitaminas, minerales y antioxidantes. Estos incluyen vitamina K, vitamina A, yodo, hierro, calcio, magnesio y ácidos grasos omega-3.
-
Promueve la salud ósea: La presencia de calcio y magnesio en la mantequilla de mar puede ayudar a fortalecer los huesos y prevenir la osteoporosis.
-
Apoya la salud de la tiroides: El yodo es un mineral crucial para el funcionamiento adecuado de la glándula tiroides. Dado que la mantequilla de mar es una buena fuente de yodo, puede ayudar a mantener la salud de la tiroides y prevenir trastornos como el hipotiroidismo.
-
Propiedades antioxidantes: Los antioxidantes presentes en la mantequilla de mar pueden ayudar a proteger las células del cuerpo del daño causado por los radicales libres, lo que puede ayudar a prevenir enfermedades crónicas y el envejecimiento prematuro.
-
Apoyo a la salud del corazón: Los ácidos grasos omega-3 presentes en la mantequilla de mar pueden ayudar a reducir los niveles de colesterol LDL («colesterol malo») y triglicéridos en la sangre, lo que puede reducir el riesgo de enfermedades cardíacas.
-
Mejora la salud digestiva: La mantequilla de mar contiene fibra dietética, que es beneficiosa para la salud digestiva al promover la regularidad intestinal y alimentar a las bacterias intestinales saludables.
Posibles riesgos y precauciones:
-
Contenido de yodo: Aunque el yodo es esencial para la salud, consumir demasiado puede causar problemas de tiroides, especialmente en personas con trastornos tiroideos preexistentes. Aquellos con hipertiroidismo o sensibilidad al yodo deben tener precaución al consumir mantequilla de mar y consultar a un profesional de la salud.
-
Toxicidad por metales pesados: Como las algas marinas pueden absorber metales pesados del agua, existe el riesgo de contaminación por metales pesados en la mantequilla de mar. Es importante obtener mantequilla de mar de fuentes confiables y limitar su consumo para reducir el riesgo de exposición a metales pesados.
-
Interacciones medicamentosas: Debido a su alto contenido de yodo, la mantequilla de mar puede interactuar con ciertos medicamentos, como los utilizados para tratar trastornos tiroideos. Las personas que toman medicamentos deben consultar a su médico antes de consumir mantequilla de mar.
-
Alérgenos potenciales: Al igual que con cualquier alimento nuevo, existe la posibilidad de alergias a la mantequilla de mar. Las personas con alergias conocidas a mariscos u otros tipos de algas deben evitarla o consumirla con precaución.
-
Contenido de sodio: Algunas variedades de mantequilla de mar pueden contener cantidades significativas de sodio, lo que puede ser problemático para aquellos que necesitan controlar su ingesta de sodio debido a condiciones de salud como la hipertensión.
En resumen, la mantequilla de mar puede ser una adición nutritiva y sabrosa a tu dieta, siempre y cuando se consuma con moderación y se tenga en cuenta cualquier riesgo potencial, especialmente en personas con condiciones de salud específicas. Es importante hablar con un profesional de la salud antes de hacer cambios significativos en tu dieta, especialmente si tienes preocupaciones sobre alergias o interacciones medicamentosas.
Más Informaciones

Por supuesto, profundicemos más en los beneficios y riesgos asociados con el consumo de mantequilla de mar:
Beneficios adicionales de la mantequilla de mar:
-
Apoyo a la salud de la piel: Los antioxidantes presentes en la mantequilla de mar, como las vitaminas A y E, pueden ayudar a proteger la piel del daño causado por los radicales libres y promover una piel saludable y radiante.
-
Regulación del azúcar en la sangre: Algunos estudios sugieren que los alginatos presentes en las algas marinas, como las que se encuentran en la mantequilla de mar, pueden ayudar a regular los niveles de azúcar en la sangre, lo que puede ser beneficioso para las personas con diabetes o en riesgo de desarrollarla.
-
Apoyo a la salud mental: Los ácidos grasos omega-3 presentes en la mantequilla de mar están asociados con la salud mental y pueden ayudar a reducir el riesgo de depresión y ansiedad, así como a mejorar la función cognitiva y el estado de ánimo.
-
Desintoxicación del cuerpo: Se cree que ciertos compuestos presentes en las algas marinas, como los alginatos y los polifenoles, tienen propiedades desintoxicantes que pueden ayudar a eliminar toxinas del cuerpo y promover la salud general.
-
Potencial para la pérdida de peso: Algunos estudios sugieren que los alginatos presentes en las algas marinas pueden ayudar a reducir la absorción de grasas y aumentar la sensación de saciedad, lo que podría ayudar en los esfuerzos de pérdida de peso.
Riesgos adicionales y precauciones:
-
Exceso de yodo en la dieta: Aunque el yodo es esencial para la salud, consumir cantidades excesivas puede provocar problemas de salud, como hipertiroidismo o tiroiditis. Es importante tener en cuenta la ingesta total de yodo de todos los alimentos, incluida la mantequilla de mar, especialmente para aquellos que consumen suplementos de yodo.
-
Contaminación microbiana: Si la mantequilla de mar no se procesa ni almacena adecuadamente, existe el riesgo de contaminación microbiana, que puede causar enfermedades transmitidas por alimentos. Es importante obtener mantequilla de mar de fuentes confiables y almacenarla correctamente para reducir este riesgo.
-
Posibles efectos laxantes: El alto contenido de fibra en la mantequilla de mar puede causar efectos laxantes en algunas personas, especialmente si se consume en grandes cantidades. Aquellos que son sensibles a la fibra deben consumirla con moderación para evitar malestar gastrointestinal.
-
Impacto ambiental: La sobreexplotación de las algas marinas para la producción de mantequilla de mar puede tener un impacto negativo en los ecosistemas marinos y en la biodiversidad. Es importante optar por productos de algas marinas que se cultiven de manera sostenible y respetuosa con el medio ambiente.
En conclusión, si bien la mantequilla de mar puede ofrecer una variedad de beneficios para la salud, es importante consumirla con moderación y tomar precauciones para evitar cualquier riesgo potencial para la salud. Como con cualquier alimento, es recomendable consultar a un profesional de la salud antes de incorporar la mantequilla de mar a tu dieta, especialmente si tienes condiciones de salud preexistentes o preocupaciones específicas.